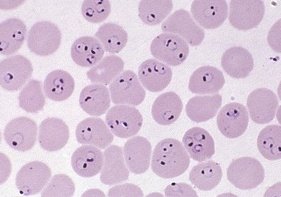
Interesting blood film from the tropics.
<a href="/underthe_scope/">margot.</a> What do you see?

Mercy Dein
@mercybuku1
Medical Laboratory Scientist/Haematologist/ Lover of God/ Etopo Energy Plc/ RSUTH, PH/HBTSS member/ Safe blood donation advocate/Proudly Kalabari😍😘
ID: 1242012583512727557
23-03-2020 08:57:53
67 Tweet
81 Followers
319 Following



Follow link to register bit.ly/3dFmP6O Dr. Tosan Erhabor YMLSF NIGERIA AMLSN Federal Ministry of Health, NIGERIA Presidency Nigeria






FULFILING PURPOSE! MINISTRY OF FOREIGN AFFAIRS PRESS RELEASE ECOWAS ENDORSE DR. NGOZI OKONJO-IWEALA FOR THE POSITION OF DIRECTOR GENERAL OF THE WORLD TRADE ORGANISATION. CONGRATULATIONS DR. Ngozi Okonjo-Iweala Greater heights. #Genevieve #leeminho_이민호 #leeminho #COVID19Nigeria


Thank you SN products Nig Ltd for recognizing and rewarding the efforts of the unsung heroes in the health sector. Follow the link below to apply. You might stand a chance of been nominated. Award is for MLS only SN Medical Unveils MLS of the Year Award premiumtimesng.com/promoted/39939…










The creation of the Directorate of Medical Laboratory Services Federal Ministry of Health, NIGERIA is not about professional territorial expansion but a necessity for technical and strategic coordination of Medical Lab. operations in-country. Cc @ehanire Miguel Mora @Mbuhari Prophet Osinbajo